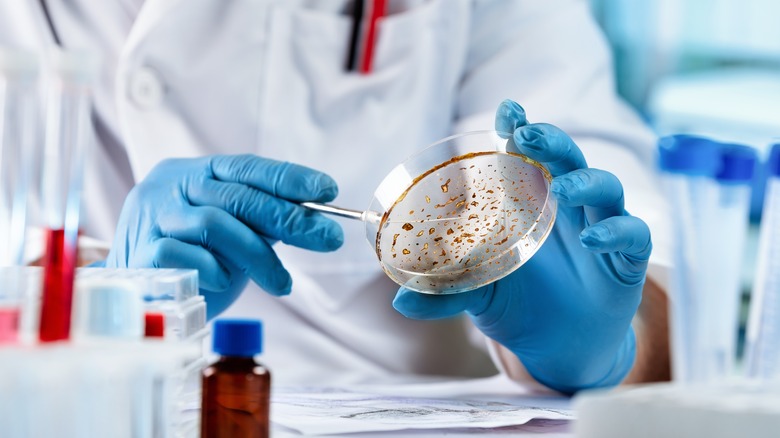
A scientist examining a petri dish

Why It's Always A Good Idea To Rinse Soda Cans
When the weather heats up, or you need a quick pick-me-up, or when you're just looking for a tasty treat to sip on, you'll likely find yourself reaching for an ice-cold can of soda. The familiar pssst sound of a soda can tab releasing its carbonated contents can be almost as satisfying as its flavor.
There are a lot of names for this famous fizzy and frothy beverage. In the American Midwest, as well as West, folks call it "pop," while in the South, soda is referred to by the seemingly brand-specific but actually generalized term "coke," per Business Insider.
Provincial slang aside, each state in the country boasts a signature soda. However, whether you're enjoying a Coloradoan Zuberfizz, New Hampshire's own Squamscot Soda, or a refreshing Rhode Island Yacht Club, you should be aware of the potentially dangerous contaminants that may have found a home on the top of your soda can.
Your soda can can be a bacterial breeding ground
Reader's Digest cites health and safety investigator Caitlin Hoff when discussing the importance of cleaning your can of soda before cracking it open. She explains that she always cleans off her cans before drinking out of them, and even wipes them down if she's planning to transfer her beverage into a fresh glass, as she feels that the lengthy journey your soda goes on before arriving in your fridge inevitably leaves it covered with contaminants. "It's important to wash the grime and bacteria that cans can collect before you drink out of a soda or open a canned good and expose the food to the bacteria on the outside of the can," Hoff detailed.
And Hoff is absolutely correct in washing her soda cans. In 2013, a team of North Texas investigators tested the tops of 20 soda cans that were sourced from a variety of locations (via CBS Dallas-Fort Worth). The petri dish marked with a sample taken from a Dallas corner market grew mold, a Dallas college campus' energy drink can had yeast on it, a restaurant chain in North Texas served up a can contaminated with staphylococcus, and a gas station energy drink tested positive for coliform, a bacteria found in animal intestines.
How to properly decontaminate your soda can
Nevertheless, The Register-Herald provides a method for sanitizing your soda cans. The publication quotes Raleigh County Health Department administrator Stan Walls' recommendation of simply rinsing your can off with hot water before cracking it open. "I would recommend washing any surface that I would be eating or drinking from because you have no idea what might have come in contact with that surface," Walls said. Additionally, CBS Dallas-Fort Worth cites Dr. Cedric Spak, a specialist of infectious diseases at Baylor University, who says that running water is one of the most effective tools you can use when cleaning your can.
While you may be tempted to use more heavy-duty cleaning tools other than a stream of water, it may not be advisable, as it isn't wise to put potentially caustic cleaning chemicals anywhere near your mouth. Drinking hand sanitizer, for example, could leave you in the hospital battling organ and nervous system damage.
Whatever the case may be, keep these tips in mind the next time you go to grab a fizzy beverage.